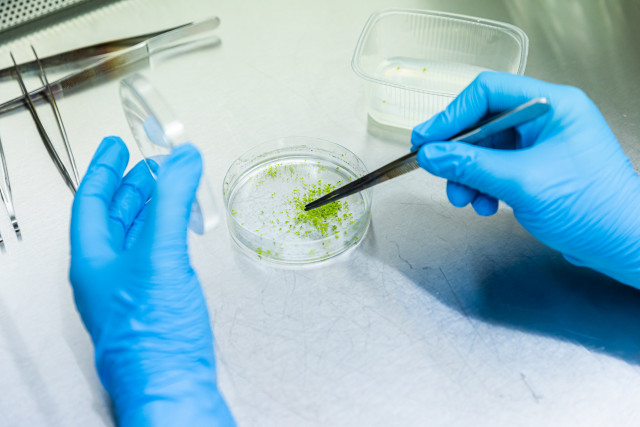

Учёные Тимирязевки создали «генетическую платформу» для выведения рапса
Учёные Тимирязевской академии завершили важный двухлетний проект, который поможет российским аграриям выращивать рапс, устойчивый к болезням. Руководителем проекта выступила доцент кафедры молекулярной селекции, клеточных технологий и семеноводства Института садоводства и ландшафтной архитектуры Анастасия Вишнякова. Общая сумма финансирования проекта за счет грантовой поддержки РНФ составила 3 миллиона рублей.
19 Август / 2025Несмотря на постоянный рост площадей, занимаемых рапсом в России, сохраняется острая проблема обеспечения аграриев высококачественным семенным материалом отечественной селекции. В частности, число зарегистрированных гибридов крайне мало. Увеличение посевных площадей под этой культурой привело к росту распространённости и вредоносности таких заболеваний, как склеротиниоз, фомоз и фузариозное увядание.
Проект Тимирязевской академии был направлен на то, чтобы научиться «программировать» рапс на устойчивость к этим болезням. Учёные собрали коллекцию различных возбудителей болезней рапса. Это помогло им создать специальные условия, где можно было проверять растения на устойчивость. Оказалось, что даже у одного грибка фомоза есть несколько «версий» генов, которые помогают ему заражать растения. Это делает обычную селекцию очень сложной. Поэтому учёные решили использовать молекулярные маркеры – это как специальные «метки» в ДНК, которые указывают на нужные гены устойчивости.
«Изучая тысячи растений рапса и других капустных культур, мы нашли те, которые почти не болеют. Например, обнаружили два образца озимого рапса, устойчивых к трём видам фузариоза, и три образца, которые плохо заражаются склеротиниозом. Это очень ценные «исходники» для будущих сортов. Некоторые растения даже показали устойчивость к очень сильным штаммам фомоза», - рассказывает Анастасия Вишнякова.
На основе этих устойчивых образцов учёные создали более 500 так называемых удвоенных гаплоидов. Это «чистые» линии растений, которые станут основой для новых, улучшенных гибридов рапса.
Было изучено более 50 молекулярно-генетических маркеров. Это как точки на карте ДНК, которые показывают, где именно находятся гены устойчивости. Учёные отобрали самые эффективные маркеры и даже разработали свою уникальную систему для быстрого определения этих генов в растениях.
Эта работа – огромный шаг вперед для российской селекции рапса. «Генетическая платформа», разработанная учёными Тимирязевки, позволит создавать новые сорта и гибриды, которые будут хорошо сопротивляться болезням. Это поможет аграриям получать стабильные и высокие урожаи, а значит, укрепит продовольственную безопасность нашей страны.
- ДРУГИЕ НОВОСТИ